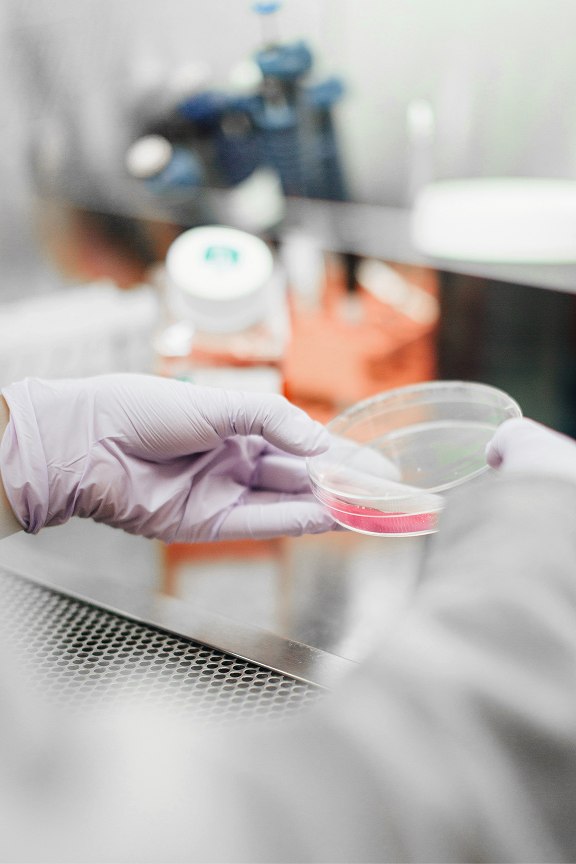
Laboratoriearbeider med lilla hansker som holder en petriskål med rød væske i et laboratorium.

GOOD
ID
AS
ESERVE
A
GO
D
ADDRESS


Oslo Science Hub blir et nytt kraftsenter for kreftforskning, innovasjon og samarbeid på Campus Radiumhospitalet.



Illustrasjon: Nordic Office of Architecture

Oslo Science Hub ønsker å bidra til et vitalt og inkluderende miljø der forskere, gründere og bedrifter fra hele Campus Radiumhospitalet kan møtes og samarbeide for å utvikle enda bedre kreftbehandling.
Fakta


Planlagt ferdigstillelse:
Kvadratmeter over bakken:
Potensielt antall ansatte:
Campus Radiumhospitalet

Foto: Oslo Universitetssykehus
.jpg)
Campus Radiumhospitalet består av Radiumhospitalet, Institutt for Kreftforskning og Oslo Cancer Cluster Innovasjonspark. Med Oslo Science Hub utvikler campus seg til en levende mikrobydel med åpne byrom og møteplasser.
Et godt sted å være for pasienter, pårørende, ansatte og naboer.
Et godt sted å være for pasienter, pårørende, ansatte og naboer.
Les mer


Film om Campus Radiumhospitalet
"When one door opens, another opens"
.png)

Menneskene
Oslo Science Hub drives av et dedikert team. Arbeidet vårt er forankret i et sterkt engasjement for kreftsaken.
Mer om menneskene

Thomas London
,
Administrerende direktør

Elisabeth Kirkeng Andersen
,
Kommunikasjonsansvarlig

Jónas Einarsson
,
Styremedlem